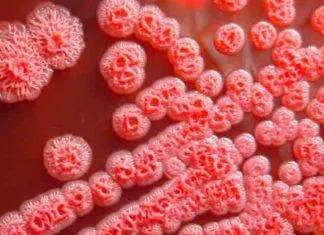

Viêm xoang là bệnh lý đường hô hấp phổ biến đặc biệt là ở nơi có đặc điểm khí hậu như Việt Nam, có thể gặp ở mọi đối tượng và với mọi lứa tuổi. Nếu không phát hiện và điều trị nhanh chóng, bệnh sẽ chuyển từ giai đoạn cấp tính sang mạn tính, gây ảnh hưởng trực tiếp đến sức khỏe và đời sống sinh hoạt hàng ngày của người bệnh.
Viêm xoang là gì?
Viêm xoang là tình trạng một hoặc nhiều xoang mà niêm mạc lót bị viêm và nhiễm trùng, gây phù nề làm tăng tiết dịch nhầy ở niêm mạc dẫn đến tắc nghẽn xoang. Tất cả mọi người và ở mọi độ tuổi đều có thể bị viêm xoang. Gọi là viêm xoang cấp tính khi bệnh diễn ra ngắn và chữa khỏi dưới 4 tuần, nếu bệnh kéo dài dai dẳng đến 12 tuần hay bị tái đi tái lại được gọi là viêm xoang mạn tính.

Nguyên nhân gây bệnh viêm xoang
Có rất nhiều nguyên nhân gây bệnh viêm xoang, trong đó có một số nguyên nhân chính sau đây:
- Do bẩm sinh: Một số người khi mới sinh ra đã bị hẹp xoang hoặc xoang quá khô gây tắc nghẽn dẫn đến tình trạng viêm và nhiễm trùng xoang.
- Do cơ địa dị ứng: Những người có cơ địa dị ứng với một số thứ như lông mèo, lông chó, phấn hoa, dị ứng hóa chất hay thuốc…đều có nguy cơ phù nề niêm mạc mũi, làm tắc các lỗ xoang dẫn đến viêm và nhiễm trùng.
- Ảnh hưởng từ các bệnh lý đường hô hấp: Đối với nơi có vị trí địa lý và đặc điểm khí hậu nhiệt đới gió mùa như Việt Nam, con người rất dễ mắc các bệnh về đường hô hấp làm hệ thống lông chuyển chất nhầy từ trong xoang ra ngoài hoạt động kém hoặc tuyến nhầy trong xoang hoạt động quá mức… cũng là lí do gây bệnh.
- Do nấm, vi khuẩn: Nấm, vi khuẩn gây bệnh phát triển trong các xoang, đặc biệt là đối với những người có sức đề kháng kém, làm viêm nhiễm và ứ đọng chất nhầy, cản trở sự lưu thông trong xoang mũi.
- Các nguyên nhân khác: Viêm xoang cũng có thể là hậu quả của một số bệnh khác như nhiễm trùng hàm trên, sâu răng, chấn thương… hay gặp ở những người có thói quen hút thuốc lá.
Việc nắm được nguyên nhân gây bệnh giúp bạn có thể tự đưa ra các phương pháp phòng tránh bệnh phù hợp với bản thân.
Triệu chứng bệnh viêm xoang
Người bị mắc bệnh viêm xoang thường thấy có các triệu chứng như hắt hơi, sổ mũi, sau đó là nghẹt và chảy nước mũi. Tuy nhiên, có một số biểu hiện của bệnh nổi bật như:
- Đau và nhức đầu: Người mắc bệnh viêm xoang đặc biệt là người bị viêm xoang trán thấy xuất hiện đau ở giữa 2 lông mày, đau 1 bên phía trên ổ mắt. Thường cơn đau tăng dần và đau nhất vào giữa trưa. Khi đau, bệnh nhân có thể kèm theo chảy nước mũi, nước mắt, chảy mủ…
- Chảy dịch mũi: Ngoài triệu chứng đau đầu, bệnh nhân viêm xoang thường bị chảy dịch mũi. Dịch này đặc, có màu vàng, xanh hoặc nâu và có mùi hôi, tanh.
- Suy nhược cơ thể, mệt mỏi, chóng mặt: Đau đầu trong thời gian dài khiến người bệnh suy nhược, mất ngủ, chóng mặt…còn dịch mũi chảy nhiều khiến bệnh nhân mất nước, gây hiện tượng chóng mặt.
- Triệu chứng khác: Ở người bị viêm xoang nặng, bạn còn có thể thấy các triệu chứng nặng mặt, sốt, giảm khả năng cảm nhận mùi, thậm chí không thể ngửi thấy mùi.

Bạn cần phân biệt được triệu chứng của viêm xoang với viêm mũi dị ứng. Bệnh viêm mũi dị ứng thường có thêm các triệu chứng như ngứa mũi, hắt hơi liên tục vào buổi sáng hoặc tối, dịch mũi trong suốt, không có màu kèm nghẹt mũi. Nắm được các triệu chứng của bệnh hỗ trợ bạn phát hiện bệnh và đưa ra hướng điều trị kịp thời.
Cách điều trị viêm xoang hiệu quả
Việc điều trị bệnh viêm xoang rất quan trọng. Nếu không điều trị dứt điểm bệnh thì bệnh có thể chuyển từ giai đoạn cấp tính sang mạn tính, tái đi tái lại nhiều lần, rất khó chữa trị và để lại hậu quả gây ảnh hưởng trực tiếp đến cuộc sống sinh hoạt hàng ngày của người bệnh.
Có 2 phương pháp chính để điều trị bệnh viêm xoang: phương pháp điều trị nội khoa và phương pháp điều trị ngoại khoa.
1. Điều trị viêm xoang nội khoa
Thực chất của phương pháp điều trị nội khoa là sử dụng thuốc. Ở mức độ nhẹ, sử dụng thuốc để chữa triệu chứng bệnh như dùng thuốc giảm đau đơn giản, thường xuyên rửa mũi hay xông mũi bằng nước muối sinh lý hoặc nước ấm. Đồng thời, kết hợp với việc thay đổi lối sống (thư giãn, nghỉ ngơi nhiều hơn). Tìm mua bộ rửa mũi chuyên dụng, dễ dùng tại đây.
Nếu các triệu chứng bệnh không thuyên giảm sau 2 ngày, bạn nên đến gặp bác sĩ chuyên khoa ngay để được chỉ định sử dụng các thuốc kháng sinh, kháng viêm hợp lý hỗ trợ tiêu diệt vi khuẩn gây bệnh.

2. Điều trị viêm xoang ngoại khoa
Khi điều trị nội khoa không đem lại hiệu quả, bệnh trở nặng thì mới nghĩ đến phương pháp điều trị ngoại khoa. Phương pháp này thường được sử dụng đối với bệnh nhân viêm xoang ở giai đoạn mạn tính. Thực chất của biện pháp điều trị này là phẫu thuật nội soi để cắt vách mũi xoang, tránh tình trạng xoang bị tắc nghẽn gây bệnh.
Tuy nhiên, các nghiên cứu chỉ ra rằng sau phẫu thuật, có đến 30 – 40% bệnh nhân có nguy cơ tái phát lại. Vì vậy, trước khi phẫu thuật, bệnh nhân cần cân nhắc kĩ càng và nên tìm hiểu thật kĩ về cơ sở y tế sẽ thực hiện phẫu thuật để đảm bảo quá trình phẫu thuật tốt nhất.
Tùy vào cơ địa mỗi người mà khả năng tái phát bệnh khác nhau. Do đó, bệnh nhân cần tuân theo phác đồ điều trị của bác sĩ và chăm sóc sức khỏe thật tốt để có sức đề kháng cao, giúp bệnh mau khỏi.
Tóm lại, viêm xoang là căn bệnh rất phổ biến ở nước ta, nó có thể gặp ở mọi lứa tuổi và mọi đối tượng. Nếu không chữa bệnh dứt điểm thì nó sẽ kéo dài dai dẳng, để lại hậu quả gây ảnh hưởng tới sức khỏe và cuộc sống của bệnh nhân.
Một số bài viết liên quan cùng chuyên mục bạn đọc có thể tham khảo:
- Triệu chứng viêm xoang và cách phòng ngừa hiệu quả
- Điều trị và phòng ngừa viêm mũi dị ứng dứt điểm tại nhà
Đừng quên tiếp tục theo dõi chuyên mục Sức khỏe của BlogAnChoi để cập nhật thêm nhiều tin tức hữu ích bạn nhé!